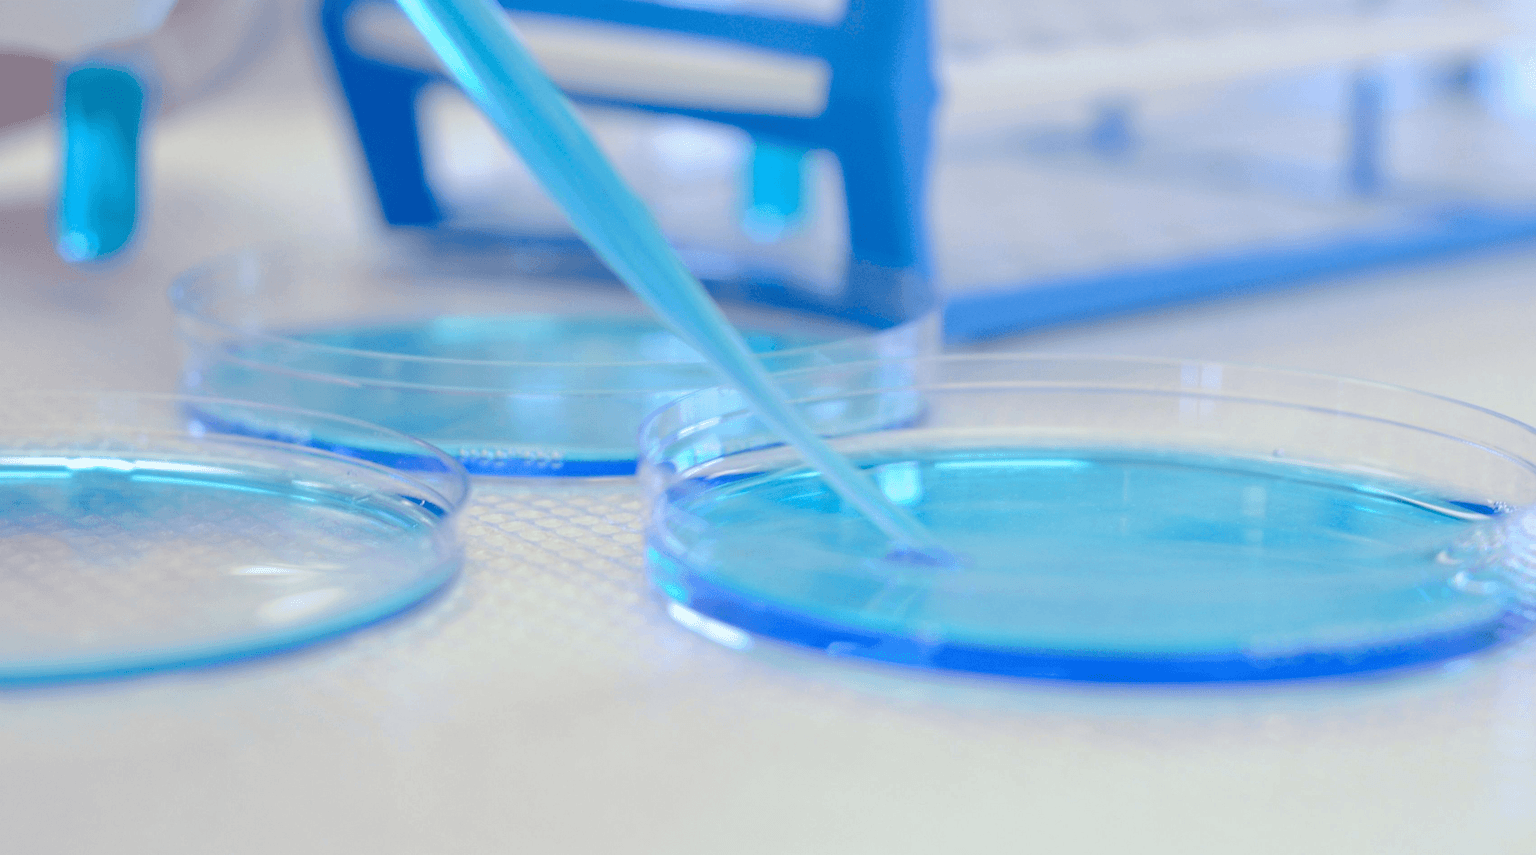
Slide 0

Transforming Discoveries
Our Bio
Our expertised, counseling and guidance teams have the experience needed to propel students towards novel educational discoveries and the development of personalized academic paths.
Top Choices
Our team features the top most colleges available that goes beyond Traditional boundaries.
We continuously invest in Top technologies to provide the highest quality of data to our students.
We are here to support you.
A member of our team will contact you shortly.
Fee Structure
CampusEntri's mission is to assist young minds bring novel success from bench to bedside.
Our use of sophisticated plan, highly responsive analyses, and insights from expert career counselors ensures a standard of excellence that enhances the effectiveness of innovative guidance.
Propelling Career Guidance & placements for free
Propelling Career Guidance & placements for free
- IAO-Accredited

- NACAC-Certified

- ECS-Complaint
- A Global Reference Team & System
Our Counselors are renowned, with expertise in several subspecialities
Our Counselors are available to serve as Principal investigators and Consultants
Our Counselors are also employed full-time and at all our locations